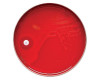

Microbiology Media Susceptibility Disks
-
 BD BBL™ Paper Discs for the Detection of Beta-Lactamase Enzymes
BD BBL™ Paper Discs for the Detection of Beta-Lactamase Enzymes -
 BD BBL™ Sensi-Disc™ Dispensers
BD BBL™ Sensi-Disc™ Dispensers -
 BD BBL™ Sensi-Disc™ Elution Discs for Susceptibility Testing of Anaerobes
BD BBL™ Sensi-Disc™ Elution Discs for Susceptibility Testing of Anaerobes -
 BD BBL™ Sensi-Disc™ Susceptibility Test Discs (L-Z)
BD BBL™ Sensi-Disc™ Susceptibility Test Discs (L-Z) -
 BD BBL™ Sensi-Disc™ Susceptibility Test Discs for Veterinary Laboratory Use
BD BBL™ Sensi-Disc™ Susceptibility Test Discs for Veterinary Laboratory Use -
 BD BBL™ Sensi-Disc™ Susceptibility Test Discs (A-K)
BD BBL™ Sensi-Disc™ Susceptibility Test Discs (A-K) -
BD BBL™ Taxo™ Discs
BD BBL™ Taxo™ Discs
